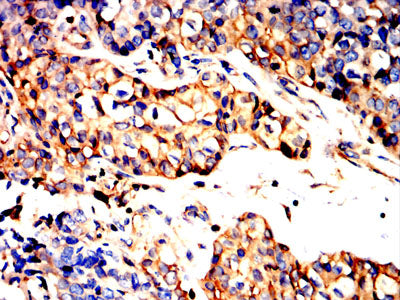

Mouse Monoclonal Antibody to AHNAK
货号:
32277
别名:
PM227; AHNAKRS
应用:
IHC,IF,FCM
反应种属:
Human
抗体类型:
Primary antibody
Swissprot:
Q09666
规格:
目录价
在线咨询
Description |
|---|
The protein encoded by this gene is a large (700 kDa) structural scaffold protein consisting of a central domain with 128 aa repeats. The encoded protein may play a role in such diverse processes as blood-brain barrier formation, cell structure and migration, cardiac calcium channel regulation, and tumor metastasis. A much shorter variant encoding a 17 kDa isoform exists for this gene, and the shorter isoform initiates a feedback loop that regulates alternative splicing of this gene. |
References |
|---|
| 1.Cancer Med. 2018 Oct;7(10):5178-5186. 2.J Proteome Res. 2021 May 7;20(5):2308-2318. |
Specification |
|
|---|---|
| Aliases | PM227; AHNAKRS |
| Entrez GeneID | 79026 |
| Swissprot | Q09666 |
| clone | 8B3A4 |
| WB Predicted band size | 63KDa |
| Host/Isotype | Mouse IgG1 |
| Antibody Type | Primary antibody |
| Storage | Store at 4°C short term. Aliquot and store at -20°C long term. Avoid freeze/thaw cycles. |
| Species Reactivity | Human |
| Immunogen | Purified recombinant fragment of human AHNAK (AA: 1-200) expressed in E. Coli. |
| Formulation | Purified antibody in PBS with 0.05% sodium azide |
Application |
|
|---|---|
| WB | 1/500-1/1000 |
| IHC | 1/200 - 1/1000 |
| IF | 1/200 - 1/1000 |
| FCM | 1/200 - 1/400 |
| ELISA | 1/10000 |
Product Image
-
Black line: Control Antigen (100 ng);Purple line: Antigen (10ng); Blue line: Antigen (50 ng); Red line:Antigen (100 ng)

-
Immunofluorescence analysis of Hela cells using AHNAK mouse mAb (green). Blue: DRAQ5 fluorescent DNA dye. Red: Actin filaments have been labeled with Alexa Fluor- 555 phalloidin. Secondary antibody from Fisher (Cat#: 35503)

-
Flow cytometric analysis of Hela cells using AHNAK mouse mAb (green) and negative control (red).

-
Flow cytometric analysis of HepG2 cells using AHNAK mouse mAb (green) and negative control (red).

-
Immunohistochemical analysis of paraffin-embedded human Cervical cancer tissues using AHNAK mouse mAb with DAB staining.

-
Immunohistochemical analysis of paraffin-embedded human bladder cancer tissues using AHNAK mouse mAb with DAB staining.

鄂公网安备42018502007531号

